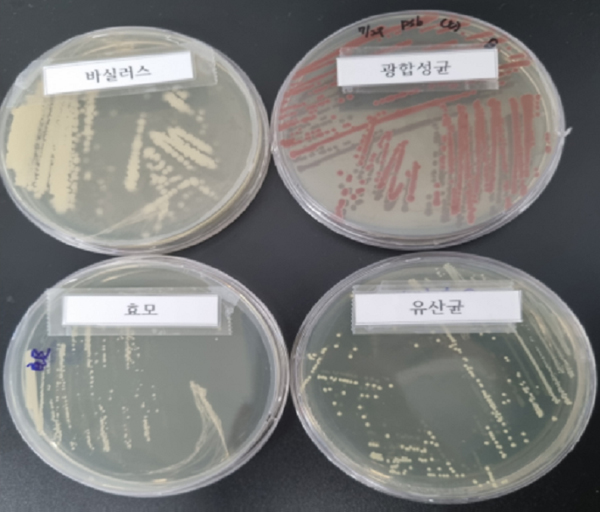

주 메뉴
주 메뉴 여닫기
주 메뉴 닫기
주 메뉴 닫기
- 기업/경제
기업/경제
기업하기 좋은 도시, 일하기 좋은 도시
김해와 함께 하세요. - 보건복지
보건복지
따뜻한 사랑으로 더불어 사는
세상을 위해 한걸음 더 나아갑니다. - 부동산
부동산
부동산, 주택, 법률 등 김해의
부동산 정보를 편리하게 찾아보세요 - 도시/건설
도시/건설
체계적인 도시디자인 계획으로
더욱 매력적인 도시가 되어갑니다. - 환경위생
환경위생
다음 세대를 생각하는
깨끗한 도시 김해, 생태환경 도시 김해입니다. - 상하수도
상하수도
깨끗한 물, 맑은 도시를 위해
상하수도사업소는
최선을 다하고 있습니다. - 재난안전
재난안전
시민의 안전을 소중하게 생각하는
김해시의 노력은
오늘도 멈추지 않습니다 - 농업기술
농업기술
농업기술센터는 농업인들과 함께
더욱 밝은 미래를 위해
함께 걷겠습니다. - 스포츠
스포츠
시민들의 건강 증진과
즐거운 여가 생활을 위해
스포츠 도시 김해가 되겠습니다. - 교육
교육
어린이부터 노인에 이르기까지
평생교육을 책임지는
인재육성 도시 김해입니다. - 교통
교통
누구나 편리하게 오고가는
스마트한 도시 교통,
김해시가 만들어가고 있습니다.

친환경미생물배양센터
시설 현황
- 위치 : 김해시 전하로 198번길 120
- 규모 : 1개소(1층, 연면적 360m2)
- 운영인력 : 2명(임기제 공무원)
- 주요장비
- 생산장비: 멸균배양기 5기, 저온저장고 5기, 자동포장기
- 실험장비: 현미경, 고압증기멸균기, 생물안전작업대 등 15종

친환경미생물배양센터 전경

친환경미생물배양센터 내 배양실

친환경미생물배양센터 내 실험실

친환경미생물배양센터 옥상
운영 개요
- 공급방식 : 매주 목요일 무상 공급
- 공급대상
- 일반농업인(경영체 등록 농가) : 1,320m2(400평)당 2L/주(상한16L)
- 도시농업인(김해시민) : 2L/주
- 생산균종 및 용도
생산균종 및 용도의 내용표 공급대상 미생물 종류 용 도 공급 기준량 비 고 농 업 인 바실러스균
광합성균
유산균
효모균- 작물 생육촉진
- 과실 당도 상승
- 토양부숙도 촉진
- 병해충 예방
- 축사 악취 제거
- 토양성질 개선 등
1,320㎡(400평)당 2L 500 ~
1,000배
희석 권장일 반 인
(도시농업인)2L 축산농가
(예정)미정 - 기대효과
- 화학비료 및 농약 사용 절감, 토질 개선, 생산성 향상, 탄소중립 실천
세부 운영방식
생산

생산균종
| 구분 | 명칭 (학명) | 보증량 | 용도 |
|---|---|---|---|
| 바실러스 | Bacillus subtilis | 1.0 x 10⁶ cfu/ml 이상 | 토양개량, 작물생육 촉진 |
| 바실러스 | Bacillus velezensis | 1.0 x 10⁶ cfu/ml 이상 | 토양개량, 작물생육 촉진 |
| 광합성균 | Rhodobacter sphaeroides | 1.0 x 10⁶ cfu/ml 이상 | 토양개량, 작물생육 촉진 |
| 유산균 | Lactobacillus plantarum | 1.0 x 10⁶ cfu/ml 이상 | 토양개량, 작물생육 촉진 |
| 효모 | Saccharomyces cerevisiae | 1.0 x 10⁶ cfu/ml 이상 | 토양개량, 작물생육 촉진 |
실험
- 실험항목 : 품질 검사 (현미경 관찰, 생균수 측정, 오염 여부 확인)
- 실시주기 : 주 1회 금주 생산균주 대상
콜로니 확인 (생균수 측정)

현미경 관찰
공급
- 공급대상 : 김해시에 주소를 두고 거주하고 있는 일반농업인, 도시농업인
- 공급방식
- 최초 방문 시 : 친환경 미생물 공급 신청서 작성, 사용법 교육 실시
- 재방문 시 : 전화 예약 후 매주 목요일 방문 → 공급 대장에 서명

친환경 미생물 배부 모습

친환경 미생물 사용법 교육 실시
친환경미생물배양
센터 담당부서 및
문의
센터 담당부서 및
문의
- 담당부서 : 김해시농업기술센터 농업기술지원과 작물환경팀
- 연락처 : 055)350-4174
- 친환경미생물배양센터 : 055)350-4178~9
- 페이지담당 :
- 농업기술지원과 작물환경팀
- 전화번호 :
- 055-350-4171
하단 정보
김해시관련
인사이드 김해
인사이드 김해 닫기
- 1 평생학습관
- 2 공공예약포털
- 3 국립김해박물관
- 4 기후변화 홍보체험관
- 5 김해목재문화박물관
- 6 김해문화재단
- 7 김해문화재단 김해가야테마파크
- 8 김해문화재단 김해낙동강레일파크
- 9 김해문화재단 김해문화의전당
- 10 김해문화재단 클레이아크김해미술관
- 11 김해문화재단 김해서부문화센터
- 12 김해문화재단 김해천문대
- 13 김해문화재단 김해한옥체험관
- 14 김해분청도자박물관
- 15 김해시 인터넷 자동차공매
- 16 김해시 중소기업육성자금
- 17 김해시교통정보
- 18 김해시도시개발공사
- 19 김해시복지재단
- 20 김해시복지재단 구산사회복지관
- 21 김해시복지재단 김해시노인종합복지관
- 22 김해시복지재단 김해시여성센터
- 23 김해시 일자리지원센터
- 24 김해의생명산업진흥원
 국가상징
국가상징 











